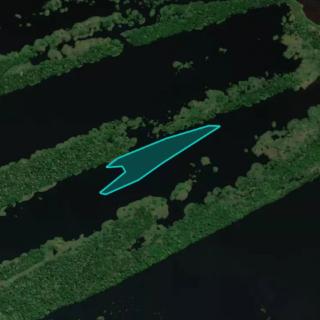

Popular Fishing Spots Near Rio Amazonas

Rio Preto Da Eva
16 mi away • Maués, Amazonas

1
Catch

Igarapé Do Velho
44.1 mi away • Autazes, Amazonas

1
Catch

Rio Amazonas
0.1 mi away • Itacoatiara, Amazonas

Rio Amazonas
0.3 mi away • Itacoatiara, Amazonas
Rio Amazonas
0.3 mi away • Itacoatiara, Amazonas

Rio Amazonas
0.4 mi away • Itacoatiara, Amazonas

Rio Amazonas
0.6 mi away • Itacoatiara, Amazonas

Rio Amazonas
1.2 mi away • Itacoatiara, Amazonas